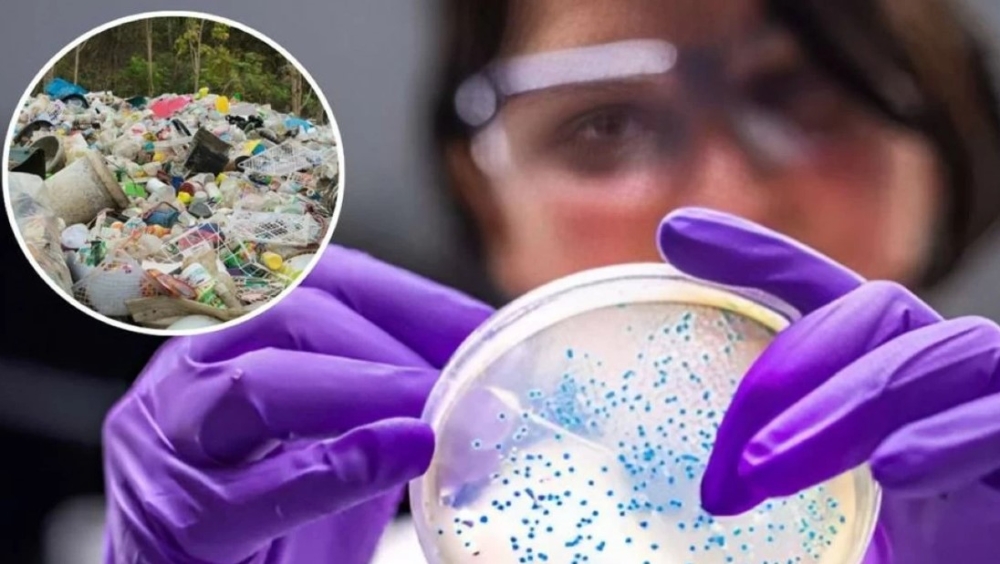

اكتشاف ثوري.. بكتيريا تحول النفايات الإلكترونية إلى موارد قيّمة
في خطوة علمية ثورية، تفتح آفاقًا جديدة لإعادة التدوير البيئي، اكتشف باحثون من كلية بوسطن بكتيريا قادرة على التغذي على مكونات البطاريات المستهلكة والنفايات الإلكترونية.
وتستخدم البكتيريا “Acidithiobacillus ferrooxidans” الحديد من البطاريات في بيئة حمضية؛ مما يؤدي إلى إذابتها وتحويلها إلى محلول مغذي يمكن استخراج الكاثودات منه لاستخدامها في بطاريات جديدة، دون الحاجة إلى إضافات سامة مثل: الكبريتات.
إعادة التدوير البيئي
وأشارت الدراسة إلى أن استخدام هذه البكتيريا يسمح بإعادة تدوير البطاريات بطريقة أكثر أمانا واقتصادية، وتأثيرًا أقل على الطبيعة، في ظل تزايد الطلب العالمي على البطاريات وتراكمها في البيئة.
وتؤكد هذه التقنية نجاح البكتيريا في استخدام مواد البطاريات وتحويلها إلى محلول مغذي، مما لا يسمح بتقليل النفايات فحسب، بل والحصول على كاثودات لبطاريات جديدة قد لا تقل كفاءتها عن البطاريات التقليدية.
ويسلط الضوء على إمكانات الطبيعة في تقديم حلول لمشاكل التكنولوجيا الحديثة.
صحيفة الرياض 24 ، موقع إخباري شامل يهتم بتقديم خدمة صحفية متميزة للقارئ، وهدفنا أن نصل لقرائنا الأعزاء بالخبر الأدق والأسرع والحصري بما يليق بقواعد وقيم الأسرة السعودية، لذلك نقدم لكم مجموعة كبيرة من الأخبار المتنوعة داخل الأقسام التالية، الأخبار العالمية و المحلية، الاقتصاد، تكنولوجيا ، فن، أخبار الرياضة، منوعات و سياحة